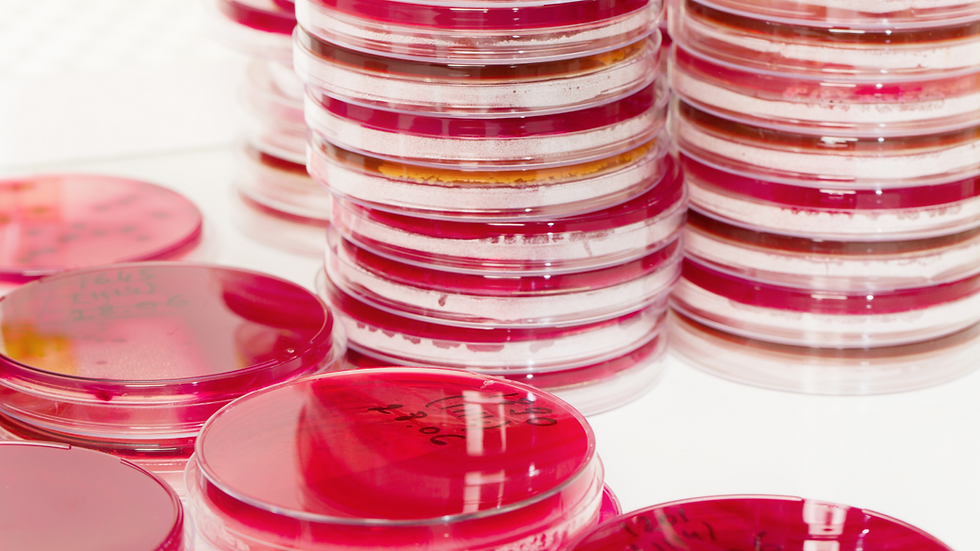
ree

SER UN ESPECIALISTA EN MICROBIOLOGIA CLINICA COMPLETO
- Verónica Seija Scaroni

- 29 dic 2022
- 2 Min. de lectura
Creo que existe la tendencia a pensar que los microbiólogos clínicos somos personas que trabajamos encerrados dentro de las cuatro paredes del laboratorio, entre muestras clínicas, placas de Petri y algún que otro equipo.
Nada más lejos de la realidad ya que para lograr ser un buen microbiólogo clínico hay que ir mucho más allá de las paredes del laboratorio.
Y ser buen microbiólogo significa no solo conocer las bases teóricas de los microorganismos, la resistencia antimicrobiana y sus métodos de diagnóstico. También implica diseñar las operaciones que van a permitir arribar a un resultado preciso, seguro y en el momento necesario para contribuir al óptimo cuidado de la salud de nuestros pacientes.
Veamos algunas de las cosas que debemos hacer para que nuestro laboratorio de microbiología clínica alcance estos objetivos.
PREANALÍTICA
Trabajar con los profesionales de la institución sanitaria para la cual trabajas para establecer las indicaciones de los estudios de diagnóstico microbiológico que se realizan.
Recomendar los métodos de obtención y transporte de las muestras clínicas. Contar con un manual escrito y un claro listado de criterio de rechazo de muestras.
ANALÍTICA
Diseñar los algoritmos internos de pruebas que se van a aplicar a las diferentes muestras clínicas recibidas: pruebas antigénicas, moleculares, cultivos, serología.
Contar con criterios estandarizados de interpretación de los resultados tanto de pruebas rápidas como de cultivos y estudios de susceptibilidad antimicrobiana.
Seleccionar los medios de cultivo, los reactivos y las pruebas más adecuadas para identificar y estudiar la susceptibilidad antimicrobiana.
Definir las muestras críticas, que requieren comunicar el resultado en forma personalizada e inmediata.
POSTANALÍTICA
Solo informar los agentes que consideramos contribuyen al proceso infeccioso. Los mismos se deben informar al personal sanitario que atiende a los pacientes de forma clara, concisa y clínicamente relevante.
Mantener una comunicación constante con los servicios clínicos, trabajando en pos de la seguridad de los pacientes.
Trabajar con los equipos sanitarios, incluidos los funcionarios de salud pública, para mejorar los procesos de diagnóstico y control de las enfermedades infecciosas, haciendo especial hincapié en la comunicación eficaz a todos los niveles.
GESTION
Desarrollar un programa integral de gestión de calidad.
Cuando aparecen nuevos estudios o nuevas metodologías, analizar el costo/beneficio de su incorporación al menú de prestaciones.
Definir indicadores de desempeño que midan procesos preanalíticos, analíticos y postanalíticos. Medirlos y generar las acciones para la mejora continua.
Gestionar los recursos humanos
Gestionar la información, los sistemas informáticos y los registros.
Estoy segura que los microbiólogos clínicos hacemos muchas más cosas pero me gustó traerles un esquema mínimo de tareas a desplegar.

Comentarios